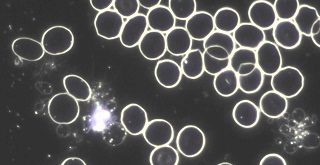

Medico Veterinario esperto in Omeopatia, Immunoisopatia, Agopuntura e Floriterapia
Alda GROSSI
Laureata in Medicina Veterinaria presso l’Università degli Studi di Pisa, ha conseguito il Diploma del corso triennale in Omeopatia Veterinaria diretta dal Dr. Franco Del Francia. Ha conseguito il Diploma della Scuola triennale di Agopuntura Energetica e Tradizionale (S.A.E.T.) presieduta dal Dr.Franco Menichelli, un Master in Immunoisopatia e, volendo approfondire le sue conoscenze di Materia Medica in chiave costituzionale-diatesica, ha scelto di orientarsi verso il Costituzionalismo Dinamico del Dr. Santini, terminando con successo un Corso Triennale in Omeopatia Dinamica organizzato dal Prof. Dario Chiriacò.
Negli anni di professione ha maturato un approccio al paziente animale in chiave Metamedica Sistemica in cui i sintomi vengono letti in chiave somato-emozionale e connessi con il “sistema” in cui vive e si relaziona l’animale stesso. La visita veterinaria diviene pluridimensionale: oltrechè lo strumento essenziale per la scelta della terapia più idonea per riportare l’armonia nell’individuo in questione, rappresenta una sicura occasione di arricchimento per i proprietari.
Ciò che è in basso è come ciò che è in alto
e ciò che è in alto è come ciò che è in basso
per fare i miracoli della cosa una.
E poiché tutte le cose sono e provengono da una, per la mediazione di una,
così tutte le cose sono nate da questa cosa unica mediante adattamento.
(Ermete Trismegisto)

Desidero lavorare per un mondo consapevole ed ordinato, in cui l’Uomo occupi responsabilmente il posto che gli compete per vivere in armonia e rispetto con tutto il Creato.

LA MIA MISSION
La mia missione è quella di proporre un approccio terapeutico eco-sostenibile, che non produca metaboliti inquinanti né incentivi la sperimentazione animale, e che contempli il paziente non solo dal punto di vista fisico, ma anche sotto l’aspetto psico-emozionale e relazionale, fino ad arrivare, ove possibile, a lavorare in maniera sistemica, relazionando l’animale al sistema umano in cui vive, e viceversa.
Quali sono i servizi offerti ?
CosaPropongo
Di seguito trovi una panoramica dei servizi che offro sia online che in visita.

Dottrina terapeutica basata sulla somministrazione di farmaci (c.d.”rimedi”) diluiti, dinamizzati, e sperimentati sull’uomo sano, prescritti sulla base dei sintomi psico-fisici peculiari del paziente. Per questioni di spazio, rimando il lettore ad altre sedi per ulteriori spiegazioni sui capisaldi dell’omeopatia, per concentrarmi sulle sue applicazioni in medicina veterinaria.
Negli animali d’affezione ne consiglio l’uso fin dalla prima infanzia (se non già nella vita intrauterina, trattando la madre): assicura al cucciolo il raggiungimento di una maturità psico-fisica equilibrata, in cui troverà sviluppo completo tutto il suo potenziale genetico e relazionale.
Pur essendo un validissimo strumento per gli stadi acuti (infezioni virali, batteriche e protozoarie), troppo spesso l’omeopatia rappresenta l’ultima chance terapeutica, per cui la utilizzo più frequentemente in soggetti geriatici, o in pazienti che versano in condizioni già molto critiche: ad esempio per insufficienze epatiche e renali, gastriti, epatiti, colangiti, enteriti; insufficienze cardiache, anemie, casi cronici di vario genere (leishmaniosi, dermatiti atopiche, immunodeficienze, allergie, patologie osteo-articolari, zoppie, artrosi, ecc.).
Per molti pazienti ha costituito una via di risoluzione definitiva, nei casi peggiori (tumori, malattie degenerative, ecc.) ha rappresentato un reale supporto al paziente: privo di effetti collaterali e tossici, che gli ha consentito di mantenere un livello di vita più che dignitoso.
La utilizzo correntemente con grandi risultati su tutte le displasie, anche quelle congenite!
Negli animali da reddito utilizzo l’omeopatia per sverminare le mandrie, ottimizzare e riequilibrare il metabolismo con conseguente ottimizzazione dell’alimento, aumento quali-quantitativo della resa (sia di latte, che di carne, che di lana) ed incremento della fertilità.
Considerando la frequenza di parto tipica degli animali da reddito, è possibile osservare l’effetto eugenetico espletato da un’ idonea terapia omeopatica sulle diverse generazioni.
A tal proposito rimando il lettore alla bibliografia di settore.
Per informazioni non esiti a consultarmi con un’email, andando alla voce “contatti”
L’immunoisoterapia è una terapia basata sugli studi di materiale biologico osservato al microscopio in campo oscuro, condotti a suo tempo dal Dr. Enderlein, biologo contemporaneo del Dr. Kock.
Kock, divenuto uno dei padri della medicina, ha dato vita al Monomorfismo, corrente scientifica su cui si basa tutta la attuale classificazione microbiologica; Enderlein, padre del Pleiomorfismo, ha invece donato la Ciclogenia, un’opera di immensa portata, base dell’attuale e poco conosciuta Teoria dell’endobionte. Su quest’ultima solo pochi paesi, quali Austria e Canada, hanno approfondito gli studi, producendo recenti pubblicazioni in campo medico-biologico. I prodotti terapeutici basati sul Pleiomorfismo costituiscono la linea Sanum.
Alla luce delle esperienze cliniche fatte utilizzando i prodotti Sanum in ambiti a dir poco disperati, mi trovo ad aver abolito da oltre 10 anni l’uso di antibiotici, di antimicotici e di antivirali. Ciò me lo son potuto permettere studiando le basi dell’Immunoisoterapia, vedendo risultati clinici inimmaginabili ed irraggiungibili con le comuni metodiche accademiche, applicate sia su pesci che su mammiferi, uccelli e rettili.
A mio avviso l’Immunoisopatia costituisce la risposta più attuale ed efficace nei confronti delle resistenze microbiche sempre più diffuse, poichè non mira ad una lotta antigenica, ma riconduce anch’essa ad un lavoro di terreno, sistemico stavolta. Coerentemente con l’omeopatia, si cura l’individuo e non la patologia. Ma in questo caso l’individuo è compreso e visto nella sua complessità microbica, nella flora saprofitica che lo compone e contemporaneamente costituisce la prima linea di difesa dell’organismo stesso.

Mediante infissione di sottilissimi aghi plurimetallici nei punti specifici dei vari meridiani, si può intervenire per sfiammare, ridurre il dolore, stimolare la cicatrizzazione, armonizzare e riequilibrare le varie funzioni organiche e metaboliche dell’organismo (disendocrinie, timpanismo, meteorismo, stitichezza, diarree emotive e nervose, problemi dermatologici).
Si può intervenire efficacemente sul tutte le problematiche osteo-articolari e legamentose (OCD, artrosi, artriti) sia a carico della colonna vertebrale che non, sia che esitino in una compressione midollare che radicolare (ad es. spondiosi, spondilomielite, spondilartrosi, Wobbler, paresi a carico dell’apparato locomotore o di porzioni di esso, paralisi degli sfinteri, ecc.).
Essendo il corpo strettamente connesso con la psiche e la sfera emotiva, agendo su di esso si affrontano e si risolvono anche le forme ansiose, le nevrosi, e le depressioni che ormai appaiono frequentemente anche nei nostri animali d’affezione (ansie da separazione, depressione dell’anziano, nevrosi compulsive, piaghe da leccamento, ecc.).
Con l’agopuntura è possibile anche intervenire sulle problematiche di ipofertilità maschile o femminile, nonchè nelle gestazioni difficili. Quest’ultimo settore è un capitolo che sta offrendo meravigliosi risultati nel campo della medicina umana (collaborazioni e ricerche con i centri di ipofertilità ed i medici agopunturisti) e che potrebbe essere applicato efficacemente anche in veterinaria.

Disciplina creata dal Dr. Edward Bach (1886 – 1936) basata sulla “solarizzazione”, cioè sull’esposizione alla luce del sole dei fiori, raccolti in determinate condizioni e periodi dell’anno, posti in boules di vetro contenenti acqua pura di fonte.
Questo procedimento consente ai fotoni di “imprintare” il supporto acquoso, trasmettendo le informazioni vibrazionali caratteristiche di ogni singolo fiore all’acqua in cui è immerso.
E.Bach ha dato vita ad un processo che oggi viene utilizzato per tutti i tipi di floriterapia: la Californiana, l’Italiana, l’Australiana, ecc. Nella mia pratica clinica mi avvalgo molto spesso della Floriterapia di Bach, della Floriterapia Australiana e di quella Italiana, nonché di Acque Vibrazionali agenti sui chakra principali.
Nella sfera psico-emotivo- relazionale uso la Floriterapia Italiana e di Bach, soprattutto come adiuvante in chi si occupa dei miei pazienti.. i proprietari!
Viceversa, la Floriterapia Australiana la utilizzo per tutte le problematiche endocrine. Esistono 10 fiori per le 10 ghiandole endocrine principali, ognuno di essi ha un’azione regolatrice ed armonizzante sulle funzioni ghiandolari, sia se lavora eccessivamente che se invece va a rilento. Sono numerosi i casi in cui all’ormone di sintesi sono riuscita gradualmente a sostituire in maniera integrale il fiore idoneo.

L’omotossicologia è una metodica terapeutica basata sugli studi del Dr.Reckweg, medico omeopata. Spesso viene confusa con l’omeopatia, di cui rappresenta uno sviluppo. “L’omotossicologia sta all’omeopatia come la foglia all’albero” amo dire, proprio per trasmettere quanto un omeopata possa usare l’omotossicologia e non viceversa. Personalmente mi avvalgo dell’omotossicologia esclusivamente quando i pazienti sono fortemente debilitati, o anziani, quando hanno poche energie e/o problemi organici da supportare. Ma la abbino sempre a dei rimedi omeopatici unitari di fondo, prescritti su base costituzional-diatesica. In tal modo aumento nettamente il ventaglio terapeutico a vantaggio del paziente, che verrà facilmente supportato anche quando versa in condizioni da ricovero.

Sono una grande sostenitrice della razione casalinga bilanciata. L’alimento fresco è sicuramente un alimento “vivo” da un punto di vista energetico, basta pensare alla vitalità che ha l’insalata in busta od il tonno in scatola rispetto agli stessi alimenti acquistati e consumati freschi.
Inoltre le proteine con i processi termici della trasformazione in crocchette o scatolette, vengono denaturate, con ovvie conseguenze sul pH del consumatore. La cottura od i trattamenti termici sono metodiche alcalinizzanti. I carnivori vanno acidificati, pertanto devono consumare proteine animali “grezze”.
Vanno molto la dieta Barf, la paleodieta.. Ma la razione deve essere equilibrata e creata ad hoc per le esigenze metaboliche del soggetto in questione. Occorre valutare lo stile di vita che l’animale conduce, il sesso, l’età, lo stadio fisiologico.. non si può alimentare un cane che esce si e no un’ora al giorno, al guinzaglio, come fosse un cane da lavoro, che dorme e vive fuori casa! Quest’ultimo riuscirà a metabolizzare perfettamente il calore prodotto dal catabolismo proteico della razione barfiana, senza risentirne a livello epatorenale.
Per saperne di più su cosa e come preparare da mangiare per il vostro beniamino peloso, non esitate a consultarmi o a seguirmi nei seminari che organizzo.

I fattori determinanti problemi di comportamento li possiamo principalmente ricondurre a: incapacità del proprietario, dieta, aberrazioni spesso causate da fenomeni che non sono stati adeguatamente presi in considerazione nella vita del paziente animale.
Mentre per le incapacità umane suggerisco di avvalersi di educatori cinofili che possano insegnare a leggere il comportamento e le esigenze canine, per ladieta e le aberrazioni noi veterinari possiamo fare la differenza.
Le diete industriali di norma sono povere in triptofano, precursore della serotonina e non solo, viceversa contengono sostanze che favoriscono l’aggressività. Per maggiori delucidazioni in dettaglio rimando a quanto riportato nella Consulenza Nutrizionale.
Per quanto riguarda le aberrazioni o i comportamenti anomali, le fisse, le paure, ecc., una buona anmnesi detttagliata come quella che richiedo previa visita e/o Consulenza Omeopatica fa decisamente la differenza. La visita o la consulenza omeopatica e quindi la relativa terapia, costituiscono a mio avviso uno degli strumenti d’elezione, da prendere quanto meno in seria considerazione, prima di iniziare a trattare l’animale con sostanze chimiche analoghe agli psicofarmaci o palliative come i ferormoni. Difatti con le prime si “sopprime” il disagio dell’animale, con le seconde si mette una “toppa ambientale”.. Entrambi i casi sono caratterizzati dalla mancata comprensione della realtà animale, e ciò può solo andare a detrimento di una sana e vera relazione uomo-animale.
Pertanto propongo come via elettiva di risoluzione dei poblemi comportamentali, la consulenza omeopatica.

La Consulenza e/o la Gestione Aziendale può essere riferita alle realtà degli allevamenti di animali d’affezione come agli allevamenti zootecnici. Le mie competenze professionali ed esperienziali spaziano dagli allevamenti di cani alle aziende zootecniche bovine, ovi-caprine, di alpache e di uccelli.
Trasformare la gestione di un allevamento da una modalità convenzionale (con utilizzo esclusivo di sostanze chimiche) ad una ecosostenibile, significa prima di tutto ridurne le spese sanitarie di oltre il 95%, aumentare la fertilità degli animali fino al 100%, avere animali sereni e ben disposti, e non inquinare Madre Terra.
I risultati si iniziano a vedere già nei primi giorni e mesi di terapia, poichè si assiste ad un generale diffuso benessere degli animali, ma la fertilità ed i frutti della scelta a monte, si vedono per bene dopo i 3-4 anni di lavoro. Infatti il lavoro omoepatico fatto sulle fattrici in gestazione determina una graduale riduzione (30%) delle patologie trasmesse di generazione in generazione. Pertanto specie nel campo zootecnico si assisteranno a rimonte completamente “nuove”, prive di tutte le problematiche presentate dalle madri e dalle nonne; rimonte che esprimeranno completamente il loro patrimonio genico migliorato dalle scelte “eugenetiche” basate sulle terapie omeopatiche in chiave costituzional-diatesica, scevro dalle azioni conseguenti all’uso dei vaccini, degli antibiotici e degli antiparassitari.
Suggerisco a riguardo la recensione dell’azienda Praces Salaro di Latina.
Cosa Fare
INVIA UNA RICHIESTA
Per prima cosa devi contattarmi usando il modulo presente in questa pagina. In questo modo, compilando i campi, potrai spiegarmi qual è il tuo problema.
RISPONDI ALLE DOMANDE
Dopo aver ricevuto la tua richiesta d’aiuto ti ricontatterò per farti delle domande specifiche sul tuo problema per comprendere a fondo qual è la soluzione migliore per te.
OTTIENI LA CONSULENZA
Per finire, quando avrò tutti gli elementi per fare una valutazione medica, ti invierò, nel minor tempo possibile, la mia consulenza per risolvere il tuo problema.
i miei Video
Ma prima di contattarmi… Cosa dicono di me?
Le Testimonianze
f.a.q.
No, l’omeopatia, agisce ovunque ci sia acqua.. quindi agisce in tutto il regno animale ed addirittura nei vegetali (si vedano le
applicazioni in campo biodinamico)
No, si può parlare di placebo nel genere umano, dove c’è uno psichismo sviluppato, ma di certo non tra gli animali o tanto meno i vegetali! Quando prescritta ed usata secondo i canoni dottrinali omeopatici, l’omeopatia funziona sempre.
Ci sono varie teorie che spiegano gli effetti dei rimedi omeopatici, ma le teorie più accreditate e recenti sono quelle relative al 4° stadio dell’acqua (si cerchi pure online, e si vedano gli esperimenti dell’equipe del Prof. E. Del Giudice, Prof. V. Elia, ecc.)
A mio personale avviso, no. Infatti i microrganismi si replicano esponenzialmente, quindi cambiano poco gli effetti rispetto alle quantità.. basta pensare a quando si va in certi paesi stranieri, dove al mattino seguente l’arrivo, la maggior parte delle persone ha dissenteria avendo solo “respirato” un’aria diversa.
Certamente si. Hanno una dentatura seghettata che permette solo di addentare e strappare, quindi deglutire quanto ingerito.
Si. Clinicamente si definisce “Vomito” l’emissione di cibo più o meno digerito a partire da 2 ore dall’ultimo pasto. Viceversa il “Rigurgito”, è un fenomeno parafisiologico nel carnivoro, ed avviene pochi minuti dopo il
pasto (di norma avvenuto voracemente) o comunque in massimo 2 ore dal pasto. Sono due meccanismi che vanno contestualizzati e letti dal medico durante il consulto o la visita veterinaria.
Direi che è fondamentale.. specie nei cuccioli in crescita. Un ritmo circadiano alterato purtroppo è sempre più frequente: le ore di veglia,
gioco, attività, in cui si attiva il Sistema Nervoso Simpatico, tendono ad essere maggiori di quelle di recupero, sonno, in cui dovrebbe viversi la fase Parasimapatica. L’eccesso di Simpaticotonia (ipersimpaticotonia) porta spesso ad alterazioni della funzione vagale sostenendo frequentemente quadri clinici caratterizzati da animali “schizzati” se non addirittura aggressivi, ansiosi.. in questi casi sono frequenti i rigurgiti, i vomiti a digiuno, notturni, leccamenti compulsivi, movimenti ripetitivi, convulsioni. Spesso tutto ciò si migliora radicalmente fino anche alla risoluzione completa dei quadri clinici, rivedendo seriamente l’alimentazione e le modalità gestionali.
In che modo posso aiutarti?
i miei Contatti
Per inviarmi una richiesta compila il modulo. Grazie!
Contatti
Attualmente svolge la sua attività ambulatoriale su Bologna e Provincia e a Roma i date programmate.
È comunque disponibile a spostarsi su richiesta per un minimo di 5 visite prenotate.

